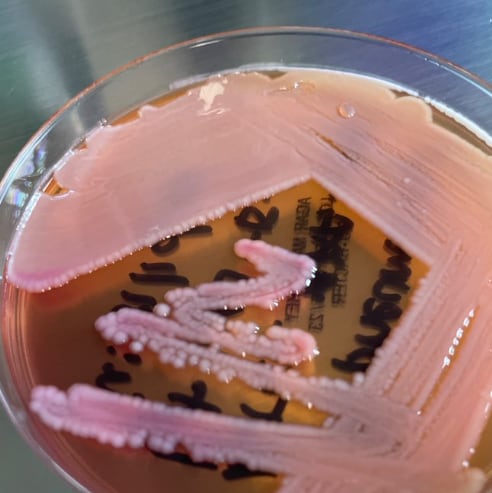

Un estudio científico ha revelado cuáles son las 5 bacterias más peligrosas del mundo.
Dicha investigación sobre los microorganismos más letales fue publicada por estudiosos en la prestigiosa revista médica británica The Lancet.
De acuerdo con los resultados presentados, estas 5 bacterias fueron responsables de la muerte de un total de 1.27 millones de personas en el 2019.
Para realizar ese estudio, se analizaron datos de 471 millones de personas en 204 países diferentes.
Además, se consideraron 23 patógenos y 88 combinaciones de enfermedades y medicamentos.

Como sabemos, el combate a las bacterias es una lucha que los humanos han tenido constantemente a lo largo de su historia.
La ciencia y la tecnología, combinadas con el instinto de supervivencia, han permitido que las sociedades controlen microorganismos y enfermedades mortales para la población.
Pese a ello, conforme avanza la humanidad, las bacterias también aumentan las posibilidades de ser un riesgo.
En ese sentido, las 5 bacterias más peligrosas del mundo son:
- Estafilococo áureo
- E. coli
- Neumococo
- Klebsiella pneumoniae
- Pseudomonas aeruginosa

Estafilococo áureo
El estafilococo áureo (staphylococcus aureus) está en la lista de las bacterias más peligrosas del mundo. Se le considera como la responsable de causar infecciones en la piel y los tejidos blandos como:



- Abscesos
- Infecciones por estafilococos
- Celulitis en la cara o cuello
La transmisión del estafilococo áureo se da por contacto con heridas quirúrgicas, la ingesta de alimentos con esta bacteria, los cuales causan vómito diarrea y cólicos.
El estafilococo áureo puede provocar afecciones mortales como lo son:
- La neumonía
- La osteomielitis
- La peritonitis
- El síndrome de coagulación intravascular diseminada

E. coli
La escherichia coli o e. coli, como también se le nombra, es una bacteria que forma parte de la microbiota del tracto gastrointestinal.
El e. coli, puede generar en los humanos infectados dolor de estomago, diarrea e insuficiencia renal en los casos muy graves.
Cabe señalar que el e.coli está presente en el intestino grueso y la materia fecal de los animales.
Se contagia tocando agua y comida contaminadas o tocando animales muertos.

Neumococo
El neumococo es la tercer bacteria más peligrosa del mundo, según el estudio de la revista The Lancet, y afecta a menores de 5 años, así como a mayores de 65.
Habría que mencionar que el neumococo es el responsable de infecciones en los oídos y senos para nasales; genera neumonía en las personas y problemas en el torrente sanguíneo.
La transmisión del neumococo, advierte la Organización Panamericana de Salud, se da por contacto directo con una persona infectada con este microorganismo.

Klebsiella pneumoniae
La Klebsiella pneumoniae es una bacteria que genera infecciones en el tracto urinario, así como:
- Neumonías
- Sepsis
- Infecciones de heridas quirúrgicas y de tejidos blandos
Los pacientes que pueden contraer la Klebsiella pneumoniae son los que se encuentran en cuidados intensivos, los alcohólicos o bebés recién nacidos.
Pseudomonas aeruginosa
La quinta bacteria más peligrosa del mundo es la pseudomonas aeruginosa. Este microorganismo se aloja en la boca y el esputo. Tiene una gran resistencia a los antibióticos.
Las personas con defensa bajas son más propensas a enfermarse de la pseudomonas aeruginosa, la cual se encuentra en el agua subterránea contaminada.
Quien se infecta con la bacteria pseudomonas aeruginosa presentará dificultades en vías respiratorias y sanguíneas.
